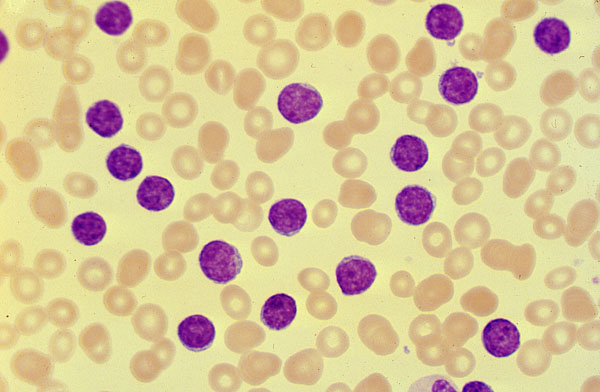

Chronic lymphocytic leukemia, peripheral blood
Click picture to enlarge. Close window to return
This patient presented with a WBC count of 130,000/ul. The white blood cells were nearly all mature appearing lymphocytes. Flow cytometry showed a B-cell phenotype typical of CLL.